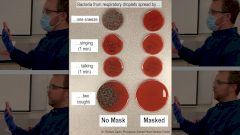
Микробиолог наглядно продемонстрировал, как и от чего защищает маска

Новости
При помощи компонента яда скорпиона возможно блокировать канал, отвечающий за рост злокачественных опухолей.
После ослабления ограничений опасность заражения остаётся. Учёные перечислили места, где она выше всего.
Журналисты обвинили президента в нарушении статьи УК «Распространение инфекционных заболеваний».
На фоне коронавирусной инфекции у музыканта развилась пневмония.
На сегодняшний день в стране зарегистрировано 700 792 случая коронавируса, из них 6562 — за последние сутки.
Таяние вечной мерзлоты может оживить вирусы чёрной оспы и других давно забытых человечеством болезней.
Такое заявление сделала официальный представитель ВОЗ Маргарет Харрис.
Жительница Мельбурна провела в коме 9 дней и скончалась.
Глава СК России Александр Бастрыкин сообщил, что найдены доказательства убийства младенца врачами в 2018 году.
Цепочка генов, вызывающая тяжёлую реакцию организма на COVID-19, сформировалась 60 000 лет назад.
Врачи Сеченовского университета и госпиталя имени Бурденко рассказали о состоянии здоровья добровольцев при испытаниях вакцины от коронавируса.
Даниэлла Альварес, мисс Колумбия-2011, опубликовала видео танца после операции.
Правительство Израиля возвращает ограничения из-за роста заболеваемости коронавирусной инфекцией.
Однако мнения о том, завышена статистика или занижена, разделились.
Это значит, что количество заболевших за сутки превышает число выздоровевших пациентов. На сегодняшний день превышение составляет около 44 000 человек.
Как будет выглядеть человек, который четверть века проведёт в карантине, работая на удалёнке?
Группа британских исследователей обнаружила пять вариаций генов, повышающих риск смерти от коронавирусной инфекции в несколько раз.
Объявлен старт народного голосования ежегодной литературной премии в области медицины «Здравомыслие»
Литературная премия в области медицины «Здравомыслие 2020» объявила о старте народного голосования.
Правила работы детских учреждений в период пандемии будут действовать до 1 января 2021 года.
Главврач больницы в Коммунарке Денис Проценко высказал своё мнение по поводу второй волны и длительности иммунитета к коронавирусу.
Учёные разработали «мембрану на чипе», которая позволяет отслеживать, как вирусы и лекарства взаимодействуют с человеческими клетками.
Американские исследователи выяснили, влияет ли астма на тяжесть заболевания коронавирусной инфекцией.
Учёный Том Джефферсон выдвинул гипотезу, что коронавирус существовал уже очень давно и был активирован, возможно, из-за плотности населения на планете.
В общем зачете печальной «олимпиады» нас опередила другая страна.
В открытом письме, подписанном 239 учёными из 32 стран, утверждается: воздушно-капельный путь передачи коронавируса гораздо более опасен, чем признаёт ВОЗ.
Ученые испытали на манекенах самые легкодоступные виды масок.
Триллеры и ужастики помогают быстрее мобилизоваться в стрессовых ситуациях.
Генно-модифицированная вакцина на основе прививки от оспы помогает организму бороться сразу с двумя белками коронавируса.
Как распространяются микрокапли слюны при кашле, разговоре и разной социальной дистанции — всё это микробиолог Рич Дэвис продемонстрировал на опытах с маской и без неё.
Глава Роспотребнадзора Анна Попова заявила, что Россия справляется с коронавирусом значительно лучше, чем другие страны.